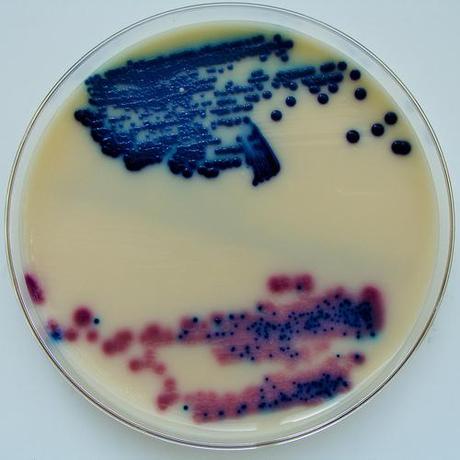
Meet Me On Monday

Sep 3, 2012 by Tatianna

Hello My Dear Lovies!
Happy Monday! Welcome to the 9th edition of Monday Mingle, a question answer game we play every Monday to get to know each other better. I couldn’t decide on the main picture for the Mingle, so I just went ahead with the cool looking one  .
.
And now, today’s questions:
- Which culture would you like to experience and why?
- Describe your perfect evening?
- Have you ever gone sky diving? If yes, describe your experience, if no would you try it?
- Do you sing in the shower?
- What are the things you love and appreciate most about your life?
My Answers:
Q – Which culture would you like to experience and why?
My Answer:
I would love to experience as many cultures as I can in my life time, I literally am fascinated by all the different cultures. This is one of my biggest dreams.
Q – Describe your perfect evening

My Answer:
A walk in a Paris at night on a lonely street, and of course dinner with authentic French food  ahhhhhh
ahhhhhh
Q – Have you ever gone sky diving? If yes, describe your experience, if no would you try it?
My Answer:
Nope, never gone and probably is the only thing in this life that I don’t think I have enough balls to try. I just can’t imagine my self jumping off a plane with someone on my back.
Q – Do you sing in the shower?
My Answer:
I don’t think I’ve ever done that not even once, maybe just for the sake of it I should try it.
Q - What are the things you love and appreciate most about your life?
My Answer:
I love absolutely everything about my life, in the past several years my life had completely changed, meaning I’ve grown up spiritually and now every day I wake up and count my blessings and thank Universe for everything my life. My life is exactly the way I want it to be and I am forever grateful for that.
Let’s Mingle my Lovies!
Hugs,
Tati




